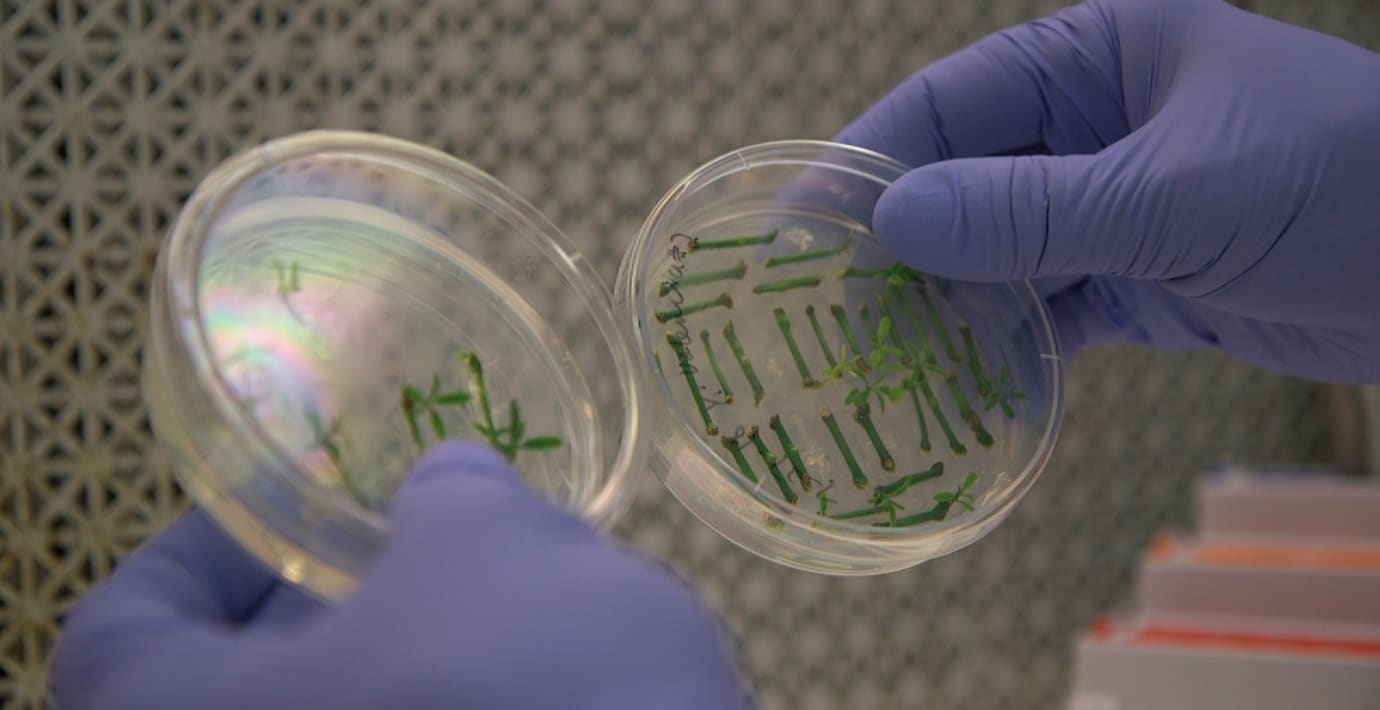

Forskare vill luckra upp regler kring genteknik
14 namn från högskolevärlden vill förenkla reglerna kring gentekniken Crispr/Cas9 i ett brev till EU-parlamentariker och regeringen. Det rapporterar SR:s Vetenskapsradion.
Forskarna menar att det blir svårare för Europa att odla miljövänliga livsmedel.
– Allt vi gör som förhindrar växtförädling gör att vi får ett mer kemikalieberoende jordbruk, säger Stefan Jansson, professor i fysiologisk botanik vid Umeå Universitet, till radion.
Crispr/Cas9-tekniken går ut på att ändra i en arts gener utan att tillföra utomstående dna, till skillnad från GMO där yttre dna kombineras med till exempel en gröda.
Läs mer
Omni är politiskt obundna och oberoende. Vi strävar efter att ge fler perspektiv på nyheterna. Har du frågor eller synpunkter kring vår rapportering? Kontakta redaktionen